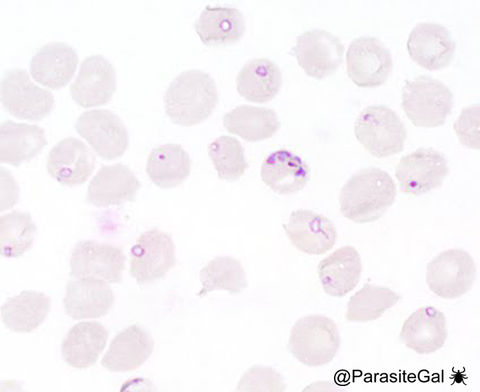
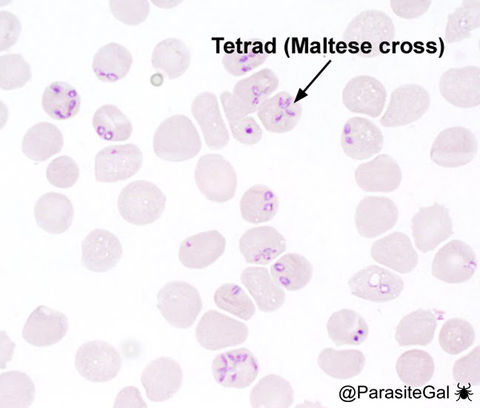

top of page
Babesia species
Babesia species
Babesia spp. are seen on thin blood films as variably-sized round, oval and elliptical forms within red blood cells. Extracellular forms are also commonly seen. Although they have a similar appearance to the ring forms of Plasmodium falciparum, they exhibit greater size and shape variability and are more likely to have extracellular forms. Rarely, Babesia spp. form the characteristic 'Maltese-cross' or tetrad form which is not seen in malaria. Other features that are helpful in differentiating Babesia from P. falciparum is the lack of malaria pigment and banana-shaped gametocytes in the former.
bottom of page